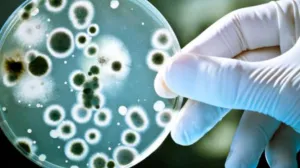
bakterija, plastika/

Šta je norovirus? Kina otkrila slučajeve u školi u Šangaju

Kina je otkrila slučajeve norovirusa u školi u priobalnom gradu Šangaju, javili su državni mediji u srijedu.
Slučajevi su otkriveni nakon što su neki učenici imali mučninu i povraćanje u srednjoj školi u okrugu Fengxian u najvećem kineskom gradu, a naknadna epidemiološka istraga pokazala je da su se učenici razboljeli od virusa.
Dok je liječenje zaraženih osoba u toku, okružni zdravstveni organ je rekao da je situacija "stabilna i da nije zabilježen nijedan teški slučaj".
"S obzirom da je proljeće vrhunac sezone zaraznih bolesti, škola će dodatno unaprijediti preventivne mjere za učenike", napominje lokalna obrazovna uprava.
Također poznat kao stomačna gripa ili stomačna buba, norovirus je vrlo zarazan virus koji uzrokuje povraćanje i dijareju.
Norovirus uzrokuje akutni gastroenteritis, upalu želuca ili crijeva, prenosi Anadolija.